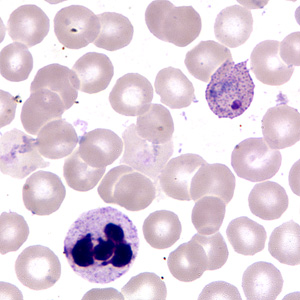
Case255_F.jpg

Case #255 – July, 2009
A 36-year-old man was admitted to the hospital with fever, chills, headache, and myalgia. The patient recently returned to the United States following a month-long trip to Rwanda to visit family. Blood was collected in EDTA and sent to the Hematology Department for work-up. Figures A–F show what was observed on a thin smear made from the blood, stained with Giemsa. All images were captured at 1000x magnification. What is your diagnosis? Based on what criteria?

Figure A

Figure B

Figure C

Figure D

Figure E
Figure F
Images presented in the DPDx case studies are from specimens submitted for diagnosis or archiving. On rare occasions, clinical histories given may be partly fictitious.
DPDx is an educational resource designed for health professionals and laboratory scientists. For an overview including prevention, control, and treatment visit www.cdc.gov/parasites/.